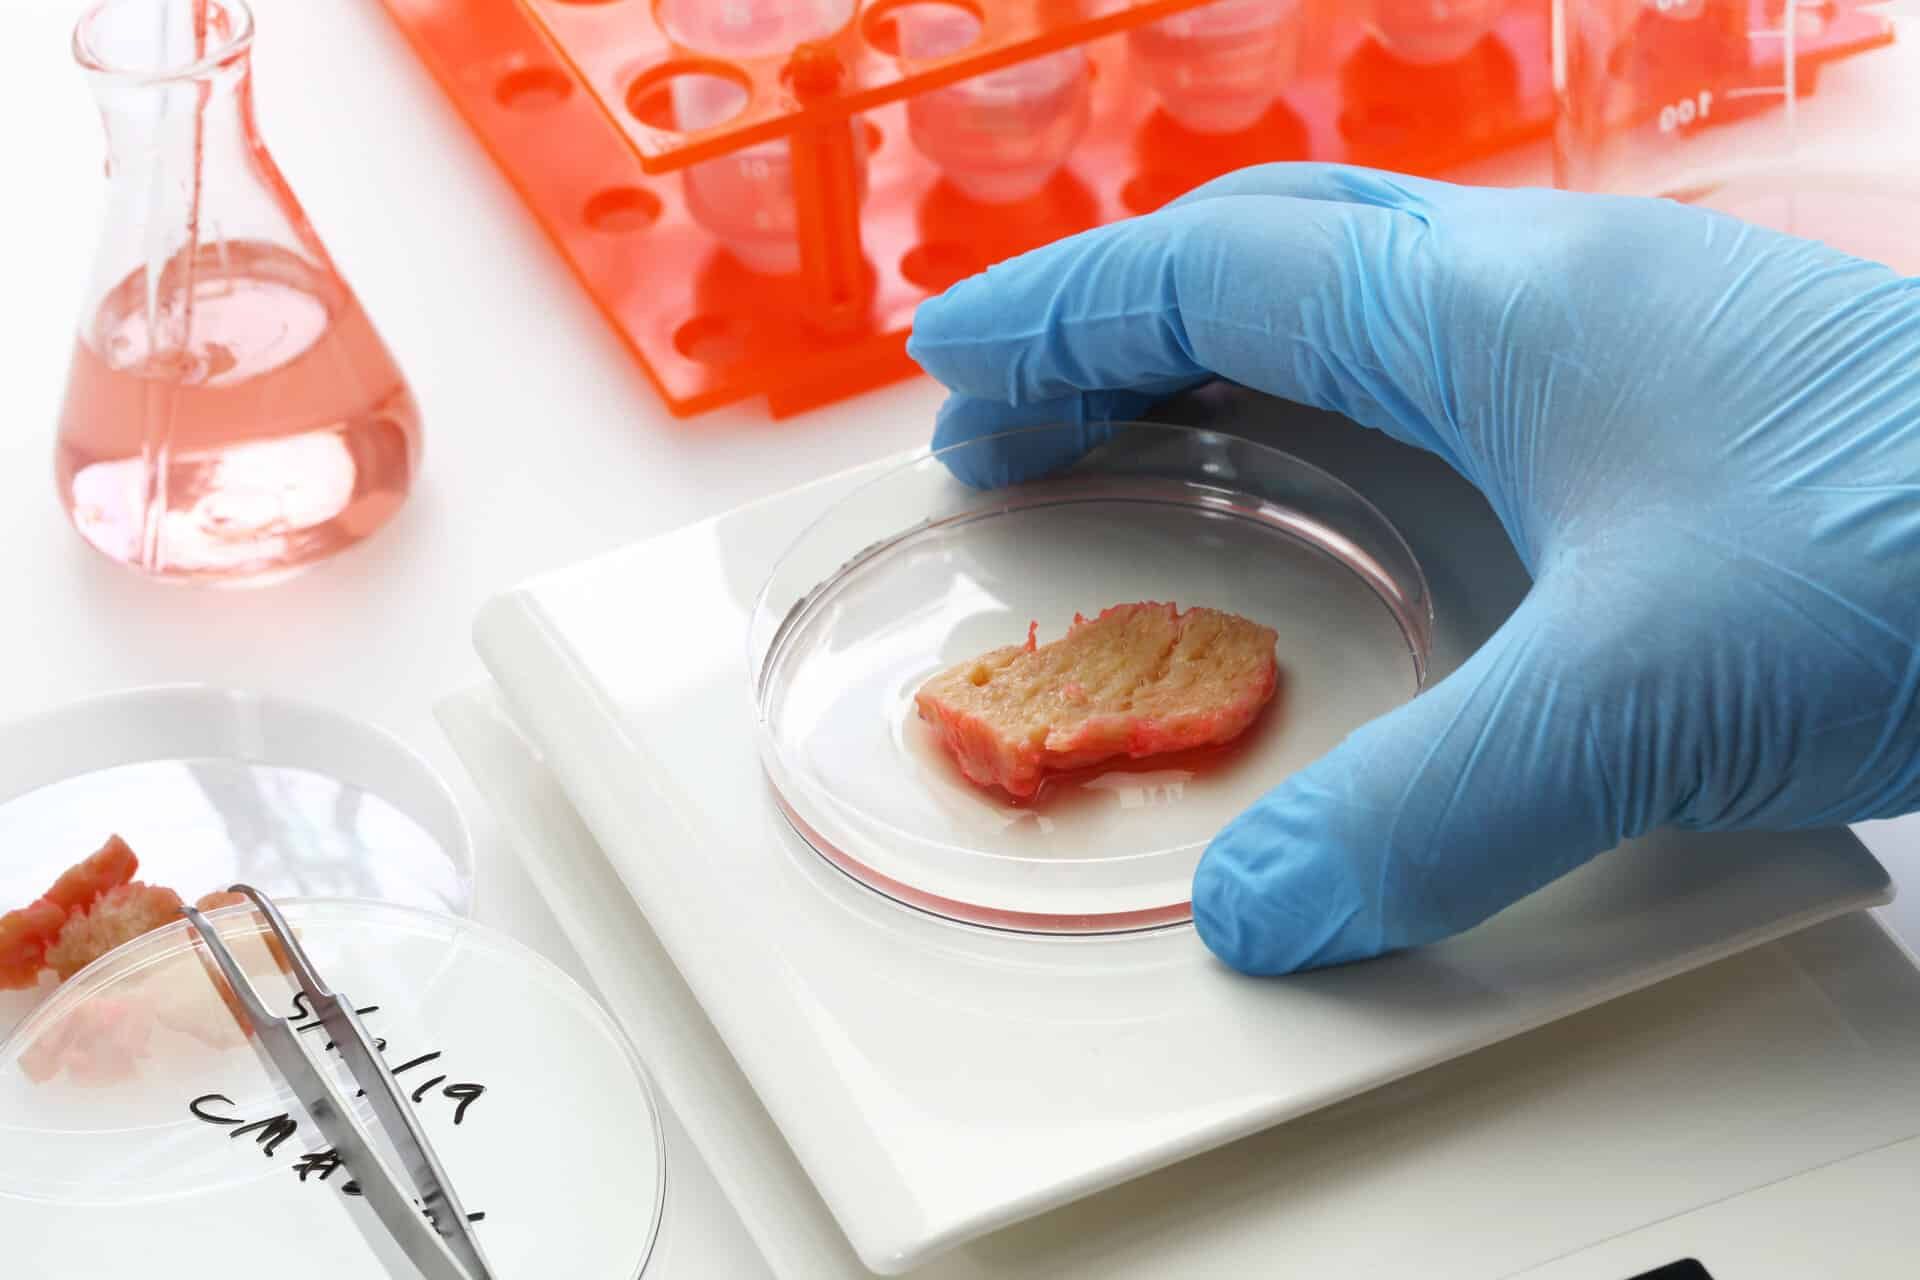

Avrupa Uzay Ajansı (ESA), uzaydaki yaşam koşullarını daha sürdürülebilir kılmak ve astronotların beslenme ihtiyaçlarını karşılamak amacıyla yapay et üretimi üzerinde önemli çalışmalara imza atıyor. Bu heyecan verici proje, astronotlar için sürdürülebilir bir protein kaynağı oluşturmayı ve böylece uzun süreli uzay görevlerinin yaşam kalitesini artırmayı hedefliyor.
ESA’nın bu yeni projesi, kültürel etin uzayda üretimi ile ilgili. Kültürel et, gerçek hayvan hücrelerinden laboratuvar ortamında üretilen ve geleneksel hayvansal etlere göre daha sürdürülebilir bir alternatif olarak görülen bir teknoloji. Yapay et üretiminin, uzaydaki sınırlı kaynakları daha verimli kullanmayı ve Dünya dışı ortamlarda beslenme ihtiyaçlarını karşılamayı amaçlıyor.
Yapay et: Uzayda sürdürülebilir bir beslenme kaynağı
ESA mühendisi Paolo Corradi, bu projenin, uzay görevlerinde kullanılan geleneksel paketlenmiş malzemelerin iki yıllık raf ömrünü aşarak, astronotlara uzun vadeli görevler sırasında besleyici yiyecekler sağlama amacında olduğunu belirtti. Ayrıca, yerinde taze yiyecek üretiminin, görevin dayanıklılığını ve kendi kendine yeterliliğini artırabileceğini, aynı zamanda mürettebat için psikolojik bir destek sağlayabileceğini vurguladı.
Yapay etin besin değerini belirlemek ve mevcut protein kaynaklarıyla karşılaştırmak amacıyla, ekipler, farklı et üretim yöntemleri ve biyoreaktör teknolojileri üzerine çalışmalar gerçekleştirdiler. ESA, bu teknolojinin henüz emekleme aşamasında olduğunu ve astronotların damak tadına uygun yapay et üretimi için daha çok araştırma ve çalışma gerektiğini belirtti.
Yapay et üretimi, hücrelerin değişen yerçekimine ve radyasyona nasıl uyum sağladığını anlamak için önemli bir fırsat sunuyor. ESA, bu konuda gerekli teknolojileri ve bilgi boşluklarını özetleyen bir yol haritası hazırladı ve yakın zamanda tesislerinde denemelere başlayacak.
Bu proje, uzayda sürdürülebilir yaşam ve beslenme konusundaki gelişmelere yeni bir perspektif sunuyor. Ayrıca, yapay et üretimi teknolojisinin, gelecekte Dünya’daki gıda güvenliği ve sürdürülebilir tarım pratiği üzerinde de olumlu etkiler yaratması bekleniyor.